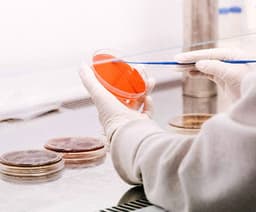
Personal Care and Hygiene

Top Priorities:
Solutions to improve efficacy of health-beneficial fractions from botanicals, including delivery systems for antioxidants, immune support, and anti-inflammatory compounds.
Clean and sustainable technologies for ensuring microbiological safety in plant-based ingredients/products while preserving functionality and managing process sterility requirements with lower Capex costs.
Tools for personalizing/customizing Ready-to-Drink/Eat (RTD/RTE) products to individual nutritional needs.
Other Areas of Interest:
- Sugar replacement bulking agents from agricultural waste valorization (Providing similar texture and functionality to sugar in various snack applications, with cost parity to sugar).
- Natural flavor and color modulation technologies (using natural or bio-based approaches, reducing reliance on synthetic flavorings).
- Technologies or initiatives that promote affordable macronutrient delivery in plant-based beverages.
- Natural ingredients that allow flavor/taste enhancement whilst reducing sugar and sweetness in beverages.